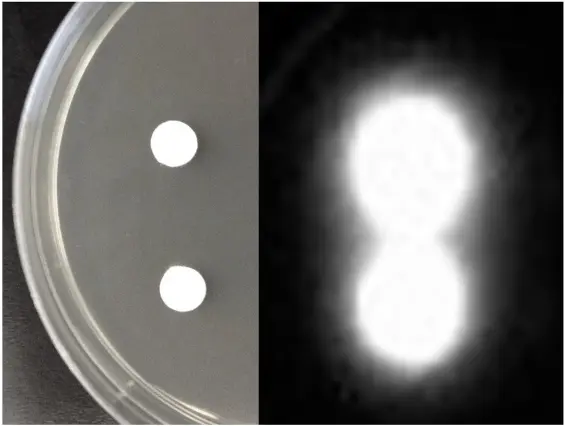

NA's Environmental Impact
Naphthenic acids (NAs) in oil sands tailings ponds are recognized as a major source of toxicity to the environment.
They are the primary contributors to the toxicity of Oil Sands Processed Water (OSPW) and have demonstrated harmful effects on a wide range of organisms, including plants, fish, amphibians, birds, and mammals.
Many NA compounds are persistent; complex multi-ring structures resist biodegradation and can remain in water for prolonged periods. As a result, tailings ponds containing OSPW pose a long-term threat to nearby aquatic life, wildlife and humans if contaminants seep or are released into rivers and wetlands.
The scale of the issue is enormous – over 1.4 trillion litres of total fine tailings have accumulated in Alberta’s tailings ponds. There is a constant need for fresh water for continued, despite efforts to reuse water for mining.
Current remediation options are limited with no established, cost-effective methods to rapidly detoxify or efficiently break down NAs. Industry practice has been to store OSPW in large ponds indefinitely, until water treatment methods have been firmly established.

Google Earth
Monitoring NA levels and toxicity in such ponds is also challenging. Companies rely on sophisticated laboratory analyses (e.g. GC-MS, LC-QTOF-MS high-resolution orbitrap mass spectrometry) to measure naphthenic acids. These methods can detect NAs at very low concentrations (down to ~0.01 mg/L) but require laborious sample preparation (such as solvent extraction) and specialized equipment and personnel. Other quick and dirty methods are available (FTIR) but they lack specificity.
Such traditional monitoring is time-consuming and costly, making it difficult to implement for continuous, long-term monitoring at scale, at multiple sites, and throughout the water cycle.
The combination of the environmental impact, massive scale, and cumbersome monitoring/remediation techniques has created an urgent need for alternative solutions to detect and manage naphthenic acid contamination in oil sands regions.
BioSensor Technology
Developing a bacterial biosensor for NAs involves considerable scientific complexity and innovation. Our researchers first identified specific bacterial strains that were isolated from and are therefore adapted to the conditions within tailings ponds water. These bacteria are abundant in tailings ponds and are well known to degrade numerous organic compounds.
Step 1. Naphthenic acids are detected inside the bacterial cell. Bacteria are highly responsive and adapt to the presence of novel organic compounds.
Step 2. Using genomic methods, we identified genes that are induced when bacteria are exposed to naphthenic acids. These include numerous genes required to degrade NA as a nutrient, but also to protect itself from the toxic NA compounds, both of which are present in the complex mixtures of NA in a tailings pond.
Step 3. Using state of the art synthetic biology and DNA printing techniques, the NA-triggered promoters were then engineered into whole-cell biosensors. The target promoters drive the expression of luminescence reporter genes (luxCDABE) in response to NA exposure.
Step 4. The biosensor produces bioluminescence in direct proportion to the amount of NA present in a water sample, which is easily measured as an indicator of NA presence.
The result was a panel of engineered bacteria, each expressing different promoters and finely tuned to light up in response to specific and unique naphthenic acid structures.
In laboratory tests, the biosensors demonstrated promising sensitivity, specificity, and reliability for NA detection. Our NA biosensors can detect individual NAs, as well as complex mixtures of NA from commercial sources, or that are purified from oil sands tailings ponds.
The detection limits achieved for NA biosensors were as low as 1.5 mg/L, which is sufficiently sensitive to detect NA in raw OSPW water. NA can also be concentrated from OSPW samples, to allow for detection in samples with low NA concentrations.
Overall, compared to conventional analytical chemistry analysis, the biosensor technology offers a simple, real-time detection method. Biosensors compromise with lower sensitivity, in exchange for rapid, specificity, reliability, exploiting the nutrient sensing capacities of bacteria. Biosensors can be adapted for in field usage, if required.
This level of sensitivity and specificity, achieved through careful genetic engineering, underscores the significant scientific effort behind the NA biosensor development. We can now easily detect naphthenic acids in water samples. In the images below, the left is an image of petri dish growing the biosensor, and naphthenic acids were spotted onto paper disks. The image on the right is the bioluminescence produced by the biosensor, directly surrounding the paper disks.
For more details on the construction and validation of this NA biosensor technology, see our first draft as a preprint publication in BioRxiv, and the final, peer-reviewed publication in the journal ACS Synthetic Biology, titled "Construction of whole cell bacterial biosensors as an alternative environmental monitoring technology to detect naphthenic acids in oil sands process-affected water".
Canadian and US patents have been submitted and are pending approval.
Regulatory Concerns
Introducing a new biosensor for environmental monitoring must align with regulatory frameworks in Canada, especially given the sensitive context of oil sands pollution.
Currently, naphthenic acids are not yet explicitly regulated by defined provincial or national standards. There are no official guidelines specifying allowable NA levels in water. The federal and provincial governments must tackle water pollution from the oil sands, and regulators are increasingly scrutinizing NAs because of their toxicity.
In 2024, the Canadian government agreed to assess listing naphthenic acids as “toxic” under the Canadian Environmental Protection Act, a step that could lead to stricter regulations on tailings water management.
This regulatory momentum means that oil sands operators will likely face enforceable limits or treatment requirements for NAs in the near future. Even under existing law (e.g. the Fisheries Act), companies are obligated to prevent discharges of deleterious substances into fish-bearing waters.
The NA biosensor technology could help industry and regulators meet these obligations by providing a tool to verify that NA concentrations, and therefore toxicity, remain below harmful thresholds before any water is released.
Gaining regulatory approval and acceptance for a biosensor-based method may have challenges. Environmental authorities will require validation that the biosensor detection is accurate and reproducible when compared to established analytical chemistry tests. The new method will need to be standardized and calibrated so that its luminescence output can be reliably translated into NA concentrations that satisfy regulatory criteria. All biosensor testing is done in a microbiology lab, and no biosensor bacteria are released into the environment. Ongoing collaborative research with the oil sands industry, as well as academic and government experts, will likely examine the technology’s performance in pilot OSPW water treatment programs. Integration with existing monitoring frameworks is key. The biosensor could be used alongside conventional water testing protocols, to support and build confidence in the implementation of this new environmental monitoring technology by the oil sand industry and regulators.